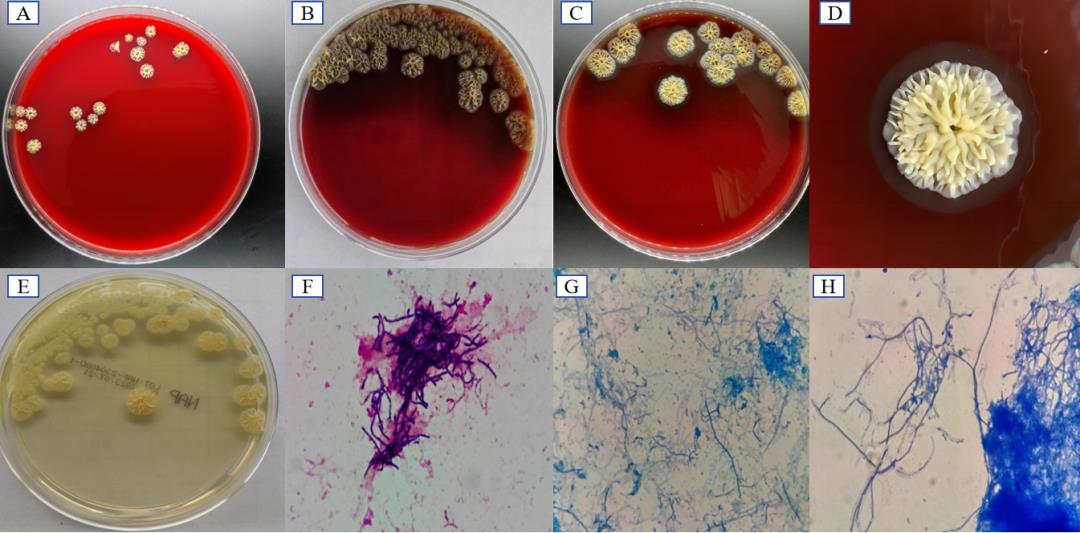

一起了解“链霉菌”相关知识
一起了解“链霉菌”相关知识
一、概述
链霉菌自1916年由Waksman和Henrici从土壤中发现后,于1943年提出建立链霉菌科。随着分子生物学工具的发展,Stackebrandt等在1997年通过16S rRNA相似性及DNA-DNA杂交的结果构建了链霉菌的系统发育树,这标志着链霉菌分子分类时期的开始,并建议将链霉菌科提升为放线菌纲中的一个亚目,命名为链霉菌亚目。2012年发布的《伯杰氏系统细菌学手册》(Bergey’s Manual of Systematic Bacteriology)中Kämpfer等将链霉菌亚目正式划分为链霉菌目。
链霉菌具有特征性的形态特点,其为革兰氏阳性需氧菌,可产生各种水溶性或脂溶性色素,有发育良好的分枝菌丝,菌丝纤细,横隔稀疏,分化为营养菌丝(又称基内菌丝)、气生菌丝。气生菌丝成熟后发育为孢子丝,孢子丝可呈直立、螺旋状、轮生等多种形态,可裂生大量分生孢子进行播撒。
1940–1970年之间的近30年被称为“抗生素发现的黄金时代”,在此期间研究人员从土壤链霉菌中发现了大量沿用至今的抗生素,如链霉素、红霉素、四环素、卡那霉素、土霉素等。有趣的是,大约三分之二的天然抗生素是由放线菌产生,其中约75%的抗生素由链霉菌属产生,链霉菌为人类医疗做出了巨大的贡献。链霉菌目前主要运用于抗生素、抗肿瘤制剂和免疫抑制剂的生产研究中,作为最具代表性的放线菌之一,是研究人员长期关注的重要功能类群。

链霉菌形态结构的模式
二、灰色链霉菌的培养特点
链霉菌属的主要代表是能产生链霉素的灰色链霉菌,其在标本中呈现革兰氏阳性的细长,不规则分枝的丝状体。

链霉菌在标本中的形态
灰色链霉菌生长缓慢,在血平板37℃可缓慢生长。培养初期菌落干燥不透明,表面粗糙,边缘不整齐,菌落陷入琼脂内,不易挑起,形成“噬琼脂”现象。随着时间的延长,菌落变大,中心凸起,逐渐形成菊花状或放射状,并产生色素和溶血环,有剧烈的土腥味。
灰色链霉菌菌落不易散开,革兰染色可见革兰阳性杆菌,有细长的不规则分枝状菌丝。该菌抗酸染色和弱抗酸染色结果为阴性。
灰色链霉菌培养特性
注:A:血平板,37℃,3d,菌落呈黄色、菊花状、放射状,轻微“噬琼脂”;B:血平板,37℃,5d,菌落产生色素C:血平板,37℃,7d,菌落开始出现透明溶血;D:血平板,37℃,7d,可见明显透明溶血环;E:血平板,37℃,5天,菌落为黄色;F:菌落革兰染色(100×);G:弱抗酸染色(100×);H:抗酸染色(100×)。

灰藻生物
专注于微生物、细胞和分子生物资源的开发和交流
兼有ATCC原装菌株
和ScienCell原代细胞代理等技术服务
致力于为任何有需要的客户
提供专业、稳定、优质的生物资源
争做“生命科学研究的好伙伴”
-

- 猫砂有什么用 养猫需要几个猫砂盆?多猫家庭要多准备一个吗?它们能并排放吗?
-
2025-11-03 15:57:19
-

- 一起来看流星雨演员表(魏晨结婚已经安排,当年《一起来看流星雨》的各位都怎么
-
2025-11-03 15:55:04
-

- 红米的手机怎么样值得购买吗 红米手机别乱买
-
2025-11-03 15:52:48
-

- 酒精度最高的啤酒 价格(酒精度高的啤酒排名)
-
2025-11-03 15:50:34
-
- 和同事产生婚外情怎么办(不小心和男同事发生了关系)
-
2025-11-03 15:48:18
-
- “碳九“是什么物质?
-
2025-11-03 15:46:04
-

- 冻豆腐的做法(白菜炖冻豆腐的做法)
-
2025-11-03 11:23:04
-

- 含有丰富维生素a的食物(猪肝里面有视黄醇)
-
2025-11-03 11:20:49
-

- 洗护发素的正确方法
-
2025-11-03 11:18:34
-

- 社保卡的社保功能有哪些(社会保障卡有什么用)
-
2025-11-03 11:16:19
-
- 辽宁竟有一个“阴魂镇”?真实存在,几户农民世代在此居住
-
2025-11-03 11:14:03
-

- 和单位同事婚外情的后果,和同事发生了婚外情
-
2025-11-03 11:11:48
-
- 爱新觉罗家族还有后人吗?
-
2025-11-03 11:09:33
-

- 西瓜总裁任利锋(最前线西瓜总裁任利锋)
-
2025-11-03 11:07:18
-

- 为什么油价又涨了-还会继续涨么-(为什么石油价格大幅上涨)
-
2025-11-03 11:05:03
-

- 对于女性来说,最晚生育年龄是多少岁?如果超了,就尽量别生了!
-
2025-11-03 11:02:48
-

- 地铁英文怎么读?到底是 “Subway“还是”Metro”?
-
2025-11-03 11:00:33
-

- 英文骂脏字口语(五句并非脏话的英语脏话)
-
2025-11-03 10:58:18
-

- 1360名解放军开国少将\仅存7人(图)
-
2025-11-03 10:56:03
-
- 哈尔滨各大商场春节期间的营业时间
-
2025-11-03 10:53:47



 飞机托运最大行李箱多少寸(行李箱尺寸对照表)
飞机托运最大行李箱多少寸(行李箱尺寸对照表) 红牛和咖啡可以一起喝吗?红牛和咖啡哪个提神
红牛和咖啡可以一起喝吗?红牛和咖啡哪个提神 黄杨木雕保养的注意事项
黄杨木雕保养的注意事项 炸肉丸放多少盐 炸肉丸放什么调料
炸肉丸放多少盐 炸肉丸放什么调料 黄河鲤鱼最大的有多大?黄河鲤鱼怎么做好吃
黄河鲤鱼最大的有多大?黄河鲤鱼怎么做好吃 地皮菜可以和木耳一吃吗?地皮菜能和木耳同吃吗?
地皮菜可以和木耳一吃吗?地皮菜能和木耳同吃吗?